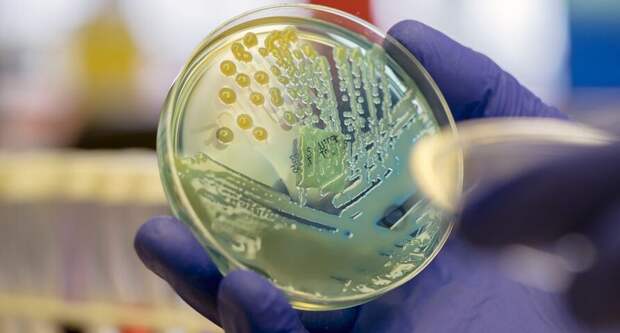

Как война России в Украине препятствует космическим исследованиям и освоению космоса
Исследование космоса может показаться далеким делом с поверхности Земли, но события на земле отражаются в космосе. Война России против Украины не является исключением.
<От системы запуска ракеты до марсохода, предназначенного для исследования Марса, широкий спектр космических миссий откладывается или отменяется в связи с полномасштабного вторжения России в Украину 24 февраля.
Европейский Союз, Соединенные Штаты и другие страны ввели санкции против России; в результате Россия постоянно меняет и отменяет свои планы, связанные с космосом. Эти изменения влияют на все — от международного сотрудничества до полетов в космос на российских ракетах.
Здесь мы подробнее рассмотрим некоторые из этих проектов.
Марсоход «ЭкзоМарс»
Миссия ExoMars — это партнерство между Европейским космическим агентством и российским космическим агентством Роскосмос. Это двухкомпонентная миссия на Марс, состоящая из орбитального аппарата и марсохода. Орбитальный аппарат находится на Красной планете с конца 2016 года, а марсоход «Розалинд Франклин» должен был быть запущен в сентябре этого года.
«Санкции и более широкий контекст делают запуск в 2022 году очень маловероятным», — говорится в заявлении Европейского космического агентства, или ЕКА, от 28 февраля в ответ на вторжение России в Украину.
В силу геометрии орбит Земли и Марса, наиболее прямая траектория полета космического аппарата с нашей планеты на Марс повторяется каждые два года, и это окно для запуска остается открытым менее двух недель. Марсоход ExoMars, который будет искать признаки прошлой жизни, первоначально планировалось запустить в 2020 году, но из-за пандемии и технических проблем запуск перенесли на 2022 год.
Теперь он снова рискует быть перенесенным на 2024 год.Телескоп eROSITA
Спектр-Рентген-Гамма — это космическая рентгеновская обсерватория, управляемая совместно Германией и Россией, которая в течение последних двух с половиной лет составляла карту крупномасштабной структуры Вселенной.
26 февраля немцы перевели eROSITA в безопасный режим, чтобы «заморозить сотрудничество с Россией», говорится в заявлении руководства SRG из Института Макса Планка в Гархинге, Германия.
«Это стандартный, обратимый режим работы телескопа, в котором мы не принимаем данные, но поддерживаем работу жизненно важных подсистем», — говорит Андреа Мерлони, астроном из Института внеземной физики имени Макса Планка в Гархинге и научный сотрудник проекта eROSITA. Он отказался комментировать какие-либо другие аспекты миссии или сотрудничества с Россией.
Российское информационное агентство ТАСС сообщило 1 марта, что Роскосмос намерен оценить финансовые потери от этой акции по безопасному режиму и других европейских санкций, связанных с космосом, после чего российское космическое агентство выставит счет «европейской стороне» проектов.
ЕКА, тем временем, «оценивает последствия для каждой из наших текущих программ, осуществляемых в сотрудничестве с российским государственным космическим агентством», говорится в заявлении агентства от 28 февраля.
Навигационные спутники
В ответ на международные санкции против России глава Роскосмоса объявил 26 февраля, что агентство приостанавливает сотрудничество с европейским космодромом в Куру, Французская Гвиана, и отзывает оттуда десятки своих сотрудников.
В следующем году с этого космодрома с помощью российской ракеты «Союз» должны были стартовать несколько космических миссий, включая пару европейских навигационных спутников в начале апреля.
Эти спутники должны были присоединиться к уже запущенным двум десяткам, которые составляют навигационную систему Galileo, европейский ответ на американскую систему GPS. На орбите также находятся еще два спутника Galileo, но они были размещены неправильно и вместо этого занимаются наукой и поисково-спасательными работами.
Интернет-сеть OneWeb
Китайская компания OneWeb, которая строит космическую интернет-сеть с помощью сотен низколетящих спутников, также откладывает запуск.
Ракета «Союз» должна была отправить в космос несколько десятков спутников OneWeb 4 марта — один из серии запусков, направленных на завершение создания сети в 2022 году.
Но рано утром 2 марта глава Роскосмоса написал в Твиттере, что космическое агентство не будет запускать спутники без гарантии со стороны компании, что они не будут использоваться в военных целях. Он также потребовал, чтобы правительство Великобритании продало свою долю в миссии, что оно отказалось сделать.
Миссия «Венера-Д» к Венере
Российско-украинская война также повлияла на космическую деятельность США, но в меньшей степени, чем ее влияние на европейских коллег.
У НАСА есть отношения с несколькими коммерческими партнерами, поэтому агентство меньше полагается на Роскосмос. Однако НАСА все еще ощущает некоторые последствия.
Например, в ответ на санкции США глава Роскосмоса 26 февраля написал в Твиттере, что участие НАСА в российской миссии «Венера-Д» к Венере будет «неуместным». Эта миссия будет включать орбитальный аппарат, посадочную и наземную станции и будет направлена на изучение бывшей и нынешней обитаемости Венеры.
Как бы то ни было, «Венера-Д» будет запущена только в конце этого десятилетия, а НАСА участвует лишь в некоторых группах планирования. У американского космического агентства уже есть две собственные миссии на Венеру.
Международная космическая станция
В то время как многие области сотрудничества в космосе с Россией терпят крах, сотрудничество по Международной космической станции пока остается неизменным.
«НАСА продолжает работать со всеми нашими международными партнерами, включая Государственную космическую корпорацию „Роскосмос“, для обеспечения безопасной эксплуатации Международной космической станции», — говорится в заявлении НАСА по связям с общественностью Джошуа Финч из Космического центра имени Кеннеди на мысе Канаверал, направленном по электронной почте.
В настоящее время на борту станции находятся два российских космонавта, четыре астронавта НАСА и один астронавт ЕКА. В конце этого месяца российская капсула «Союз» должна вернуть двух космонавтов и одного из астронавтов НАСА на Землю, приземлившись в Казахстане, как и было запланировано, сказал Финч.
По словам Финча, в конце этого месяца российская капсула «Союз» вернется на Землю.
Однако на заседании Консультативного совета НАСА 1 марта Уэйн Хейл, бывший помощник администратора НАСА, рекомендовал американскому космическому агентству рассмотреть запасные варианты на случай, если Россия больше не будет сотрудничать с космической станцией.
На том же заседании на следующий день бывший представитель США Джейн Харман рекомендовала НАСА подумать о том, как будет выглядеть сотрудничество с Россией в будущем.
Другие научные коллаборации под угрозой
Космические исследования — не единственная область науки, испытывающая неопределенность в связи с войной России против Украины.
Вот два других научных сотрудничества, которые демонстрируют признаки напряженности.
Ядерный синтез
На юге Франции международная группа физиков строит ИТЭР, который станет крупнейшим в мире экспериментом по физике плазмы для производства энергии таким же образом, как это делают звезды в своих ядрах.
Семь партнеров — включая Европейский Союз, Россию и США — возглавляют проект и разрабатывают оборудование, используемое в эксперименте. Пока никто не знает, каковы будут последствия для ИТЭР, потому что это «ситуация, не имеющая прецедента», заявила организация ИТЭР в своем твиттере 2 марта. — Лиз Круэзи
Исследование Арктики
С момента создания Арктического совета в 1996 году восемь его полноправных членов, включая Россию и США, заключили соглашения по вопросам, начиная от планов ликвидации разливов нефти и заканчивая научным сотрудничеством, что привело к номинациям на Нобелевскую премию мира, в том числе в 2022 году.
Пока неясно, как война повлияет на это сотрудничество или на другие международные арктические усилия, такие как совместное патрулирование Берингова моря между Россией и США и план ЕС и России по извлечению затонувших атомных подводных лодок из российских вод.
-
Telescope WebBibe Джеймса получил свою научную орбиту
Космический телескоп «Джеймс Уэбб» прошел на вторую точку Лагранжа.
В течение следующих 5−10 лет это его рабочая орбита, где он должен начать свои наблюдения летом.
24 января телескоп по имени Джеймс Уэбб в течение пяти минут запустил свои двигатели и сделал полную коррекцию курса, что привело его на рабочую орбиту на второй точке Лагранса.
Это расстояние почти полтора миллиона километров от Земли, откуда он летел в течение 29 дней. За это время телескоп удалось завершить все этапы своего развертывания примерно через 26 минут.
Телескоп ожидает 5−10 лет работы, пока до начала первых наблюдений он должен завершить пятимесячное обучение, в течение которого он должен остыть до рабочей температуры и настроить оптическую систему и откалибровать научные инструменты.
-
«Вечный» пузырь продержался более года, не лопнув
Если вы ненавидите, когда ваш мыльный пузырь лопается, вам понравятся эти «вечные» пузыри.
В то время как мыльные пузыри известны своим хрупким строением, новые пузыри могут продержаться более года, прежде чем лопнут, сообщают ученые 18 января в журнале Physical Review Fluids.
Вместо мыла и воды пузырьки изготавливаются из воды, микрочастиц пластика и прозрачной, вязкой жидкости под названием глицерин. Это трио ингредиентов предотвращает факторы, которые обычно ускоряют смерть пузыря.
В обычном мыльном пузыре гравитация тянет жидкость ко дну пузыря, оставляя сверху тонкую пленку, которая может легко разорваться. Испарение жидкой пленки также снижает выносливость пузырей. В вечных пузырях частицы пластика прилипают к воде, поддерживая толщину пленки. Тем временем глицерин поглощает влагу из воздуха, противодействуя испарению.
«Когда мы обнаружили, что пузырь не лопается через несколько дней, мы были очень удивлены», — говорит физик Майкл Бодуэн из Университета Лилля во Франции. Поэтому он и его коллеги стали ждать, как долго продержатся пузырьки. И ждали, и ждали. Один пузырь продержался 465 дней, прежде чем лопнул, что сделало его самым долгоживущим пузырем из когда-либо созданных в нормальных атмосферных условиях. Перед тем как лопнуть, пузырь слегка позеленел, что является возможным намеком на то, что привело к его окончательному разрушению. Вероятно, микробы поселились там, ослабив структуру пузыря, подозревает команда".
-
Ученые раскрыли секрет успешной охоты рыбацких кошек
Когда знаменитая загадочная рыбацкая кошка охотится в глубокой воде, она сохраняет спокойствие и не шевелится. По крайней мере, большую часть времени.
Азиатская кошка Prionailurus viverrinus по ночам рыщет по болотам и топям в поисках рыбы, которая могла бы стать питательной пищей. В зависимости от глубины воды дикая кошка меняет стратегию охоты, чтобы максимально увеличить количество энергии, сообщают ученые 24 декабря в журнале Mammalia.
По словам соавтора Тиасы Адхья, биолога из Калькутты, доклад предлагает «первый детальный взгляд на то, как охотится рыбацкая кошка». Один из ведущих экспертов по этому виду, Адхья в 2010 году стал одним из основателей проекта «Рыболовная кошка» — самого продолжительного в мире проекта по изучению и сохранению рыболовных кошек.
В 2010 году он стал одним из основателей проекта «Рыболовная кошка».
Чуть более десяти лет назад рыбацкая кошка была одним из наименее изученных диких животных в мире. Чтобы повысить осведомленность местного населения и собрать данные о кошке среднего размера, в 2016 году проект запустил инициативу «Знай своего соседа». Более 20 человек, проживающих вблизи трех основных мест обитания рыбацких кошек на восточном побережье Индии, включая Чилику, крупнейшую солоновато водную лагуну в Азии, были обучены установке камер-ловушек в своих районах.
Один из добровольцев, Субас Бехера, — рыбак, живущий недалеко от Чилики в деревне Бхусандапур. Каждый вечер Бехера устанавливал фотоловушку в заранее определенном месте и снимал ее на следующее утро, чтобы избежать кражи или повреждения. Он с большой любовью назвал самку рыбацкой кошки, зафиксированную его фото ловушкой, «Чоти», что означает «маленькая», в честь ее одной короткой задней лапки.
«Рыбацкая кошка думает так же, как рыбак, — говорит Бехера. «Мы оба постоянно думаем о том, где находится рыба».
Дивьяджйоти Гангули, студент магистратуры по биологии дикой природы в Национальном центре биологических наук в Бангалоре и соавтор исследования, проанализировал 197 видео, собранных фото ловушками с 2016 по 2018 год.
На большой глубине, где большая часть тела кошек погружена в воду, кошачьи, как правило, терпеливо ждут удобного случая для удара. Они оставались неподвижными почти 52% времени, а прыгали за добычей всего 3,9% времени.
В этом случае, как показали видеозаписи, кошки не двигались.
Такой подход «сидеть и ждать» помогает кошкам-рыболовам экономить энергию и одновременно повышает шансы на успешное нападение на добычу. Рыбацкая кошка «хорошо думает, прежде чем прыгнуть в воду», — говорит Адхия. «Она должна оптимизировать свой [энергетический] выигрыш»
По словам Гангули и Адхья, во время охоты на мелководье рыболовные кошки были более активны, патрулировали около 96% времени и иногда били лапами по воде, чтобы вымыть рыбу.
Это исследование «расширяет и углубляет наше понимание полу водной природы рыбацкой кошки», — говорит эколог Джим Сандерсон, основатель и директор Фонда сохранения малых диких кошек в Корралесе, штат Нью-Мексико, который не принимал участия в исследовании.
Ягуары в Бразилии были замечены за рыбалкой. Но кошки-рыболовы имеют реальную физическую адаптацию к полу водному образу жизни. Их частично втягивающиеся когти позволяют кошкам зацеплять и удерживать рыбу, а их двухслойная шерсть помогает им оставаться сухими, как показали предыдущие работы. Рыбацкая кошка — одна из двух диких кошек в мире, приспособленных к полу водному образу жизни, вторая — плоскоголовая кошка (Prionailurus planiceps) из юго-восточной Азии.
Пока еще многое предстоит узнать о рыбацких кошках, в том числе и то, сколько их всего в мире. На сегодняшний день ни в одной из 10 стран, в которых известна эта кошка, не проводились национальные подсчеты. Кошки сталкиваются с растущей угрозой потери и деградации среды обитания, а также с конфликтами между человеком и животными, в результате чего Международный союз охраны природы классифицировал этот вид как уязвимый.
«Жизнь за счет рыбы неизбежно приводит к тому, что рыболовные кошки вступают в конфликт с людьми, делающими то же самое, — говорит Сандерсон. «Вот почему сохранение рыболовных кошек подразумевает работу с местным населением».
-
Застряли в доме этой зимой? Попробуйте реализовать домашний научный проект
Для многих из нас сейчас самый разгар зимы, суровая погода и пандемия заставляют нас сидеть дома. Если вы ищете новый способ скоротать время, почему бы не помочь науке?
Исследователи самых разных дисциплин используют возможности краудсорсинга для сбора и анализа данных. От расшифровки метеорологических журналов викторианской эпохи до классификации африканских животных, пойманных с помощью фотоловушек, — вот лишь несколько способов использовать свободное время с пользой.
Вот и все.
Охотник за солнечными струями
Цель: создание базы данных солнечных струй
КАК ПОМОЧЬ: Обсерватория солнечной динамики НАСА, или SDO, следит за активностью Солнца уже более десяти лет. Изучение вспышек на Солнце, в том числе узких струй плазмы, вырывающихся с поверхности, поможет ученым лучше понять космическую погоду и раскрыть солнечные тайны. Но сначала исследователям нужно найти эти струи. Вот тут-то вы и другие астрономы в креслах и приходят на помощь. Просто зайдите в Интернет, просмотрите последовательность снимков SDO, определите, видны ли солнечные струи, и задокументируйте подробности этих событий. Помимо того, что эти данные помогут ученым изучать Солнце, они могут помочь в создании компьютерной программы, которая ускорит процесс идентификации солнечных струй в будущем.
Спасатели в море
ЦЕЛЬ: Расширить климатическую летопись в глубь веков
КАК ПОМОЧЬ: Чтобы оценить сегодняшние изменения климата в перспективе, ученым необходим длительный учет глобальных температур. Эти данные довольно хороши для 20-го века, но в 19-м веке они были более пятнистыми. Чтобы восполнить пробелы, исследователи оцифровывают метеорологические журналы с кораблей, плававших в середине 1800-х годов. Любой человек, имеющий выход в Интернет (и готовый прочитать старинный скорописный почерк), может помочь расшифровать богатейшие данные, хранящиеся в этих книгах.
Сообщественная совместная сеть наблюдения за дождем, градом и снегом
ЦЕЛЬ: Улучшение качества данных об осадках
КАК ПОМОЧЬ: Поскольку осадки в виде дождя и снега настолько изменчивы даже на небольших расстояниях, лучший способ точной оценки осадков — это как можно больше измерений на месте. Именно эту цель преследует сеть добровольцев из США, Канады и Багамских островов, которые ежедневно измеряют количество осадков в своих дворах. Имея одобренный проектом дождемер и пройдя онлайн-обучение, вы сможете собирать данные, которые пригодятся всем — от фермеров и городских управляющих до Национальной метеорологической службы.
Поиск лягушки
Цель: следить за лягушками, находящимися под угрозой исчезновения
КАК ПОМОЧЬ: Чтобы следить за видами лягушек, которым грозит исчезновение, ученые из Австралии установили устройства акустического мониторинга в нескольких национальных парках страны. Исследователи ищут добровольцев для прослушивания многочасовых записей. Просто зайдите в Интернет, изучите полевой справочник лягушачьих голосов и начните определять земноводных по аудио клипам.
Проект «Колючая груша» Кении
Цель: Оценка воздействия инвазивного растения
КАК ПОМОЧЬ: Инвазивные кактусы колючей груши распространяются по всей Восточной Африке. Чтобы узнать, как эти растения могут изменить поведение местных диких животных, экологи установили в Кении фото ловушки. Ученые могут помочь задокументировать то, что присутствует на более чем 100 000 фотографий. Пройдя онлайн-учебник, вы сможете каталогизировать все — от трубкозубов до зебр, которых вы видите.
Найти Рико
Цель: выявить гениальных собак
КАК ПОМОЧЬ: В 2004 году исследователи представили миру Рико, колли, который распознавал около 200 произносимых слов. Теперь ученые ищут новых собак с высоким словарным запасом для изучения собачьего интеллекта и языковых навыков. Если ваш питомец знает хотя бы 20 предметов по имени, команда хочет услышать это от вас.
-
Как искусственный интеллект может идентифицировать людей даже в анонимизированных массивах данных
То, как вы взаимодействуете с толпой, может помочь вам выделиться из нее, по крайней мере для искусственного интеллекта.
Получив информацию о взаимодействии целевого человека с мобильным телефоном, а также о взаимодействии его контактов, искусственный интеллект может правильно выбрать цель из более чем 40 000 анонимных абонентов мобильной связи более чем в половине случаев, сообщают исследователи 25 января в журнале Nature Communications. Полученные данные свидетельствуют о том, что люди социализируются таким образом, что их можно использовать для выделения из наборов данных, которые якобы анонимизированы.
Не удивительно, что люди стремятся оставаться в рамках устоявшихся социальных кругов и что эти регулярные взаимодействия формируют устойчивую модель со временем, говорит Джайдип Шривастава, компьютерный ученый из Университета Миннесоты в Миннеаполисе, который не принимал участия в исследовании. «Но тот факт, что вы можете использовать этот шаблон для идентификации личности, является удивительным»
Согласно Общему положению о защите данных Европейского союза и Калифорнийскому закону о конфиденциальности потребителей, компании, которые собирают информацию о повседневном взаимодействии людей, могут передавать или продавать эти данные без согласия пользователей. Загвоздка в том, что данные должны быть анонимизированы. Некоторые организации могут предположить, что они могут соответствовать этому стандарту, давая пользователям псевдонимы, говорит Ив-Александр де Монтжойе, исследователь вычислительной конфиденциальности в Имперском колледже Лондона. «Наши результаты показывают, что это не так»
Де Монтджойе и его коллеги выдвинули гипотезу о том, что социальное поведение людей можно использовать для выделения их из массивов данных, содержащих информацию о взаимодействии анонимных пользователей. Чтобы проверить свою гипотезу, исследователи научили искусственную нейронную сеть — ИИ, который имитирует нейронную схему биологического мозга — распознавать закономерности в еженедельных социальных взаимодействиях пользователей.
Для одного из тестов исследователи обучили нейронную сеть, используя данные неизвестной службы мобильной связи, в которых подробно описывались взаимодействия 43 606 абонентов в течение 14 недель. Эти данные включали дату, время, продолжительность, тип взаимодействия (звонок или текст), псевдонимы участвующих сторон и инициатора общения.
В одном из тестов нейронная сеть была обучена на данных, полученных от неизвестного сервиса мобильной связи.
Данные о взаимодействии каждого пользователя были организованы в веб-структуре данных, состоящие из узлов, представляющих пользователя и его контакты. Строки с данными о взаимодействии соединяли узлы. ИИ показывали паутину взаимодействия известного человека, а затем давали команду искать в анонимизированных данных паутину, которая имела бы наибольшее сходство.
Нейронная сеть связала всего 14,7% людей с их анонимными личностями, когда ей показали сети взаимодействия, содержащие информацию о телефонных контактах объекта, которые произошли через неделю после последних записей в анонимном наборе данных. Но он идентифицировал 52,4% людей, когда ему была предоставлена информация не только о взаимодействиях объекта, но и о взаимодействиях его контактов. Когда исследователи предоставили ИИ данные о взаимодействии цели и контактов, собранные через 20 недель после анонимного набора данных, ИИ по-прежнему правильно определял пользователей в 24,3% случаев, что говорит о том, что социальное поведение остается идентифицируемым в течение длительного периода времени.
Чтобы проверить, может ли ИИ профилировать социальное поведение в других местах, исследователи протестировали его на наборе данных, состоящем из четырех недель данных о близком соседстве с мобильных телефонов 587 анонимных студентов университета, собранных исследователями в Копенгагене. Эти данные включали данные о взаимодействии, состоящие из псевдонимов студентов, времени встречи и силе принимаемого сигнала, который указывал на близость к другим студентам. Эти метрики часто собираются приложениями для отслеживания контактов COVID-19. Получив цель и данные о взаимодействии ее контактов, ИИ правильно определил студентов в наборе данных в 26,4% случаев.
Выводы, отмечают исследователи, вероятно, не применимы к протоколам отслеживания контактов Google и системе уведомлений Exposure Notification от Apple, которая защищает конфиденциальность пользователей, шифруя все метаданные Bluetooth и запрещая сбор данных о местоположении.
Де Монтджойе говорит, что надеется, что исследование поможет разработчикам усовершенствовать стратегии защиты личности пользователей. По его словам, законы о защите данных позволяют обмениваться анонимизированными данными для поддержки полезных исследований. «Однако для того, чтобы это работало, необходимо убедиться, что анонимизация действительно защищает частную жизнь людей»
-
Золотые и серебряные трубки в российском музее — самые древние из известных соломинок для питья
Восемь серебряных и золотых трубок, хранящихся в российском музее, долгое время считались церемониальными посохами или опорами для балдахина. На самом деле эти длинные трубки являются древнейшими из сохранившихся соломинок для питья, утверждают исследователи.
По мнению археолога Виктора Трифонова из Российской академии наук в Санкт-Петербурге и его коллег, люди использовали эти высококлассные соломинки для питья пива из общего сосуда более 5 000 лет назад. При раскопках в 1897 году на территории нынешней Армении металлические трубки, украшения и другие предметы были обнаружены в кургане, из Майкопской культуры, которая датируется периодом между 5 700 и 4 900 годами назад.
Соломинки были найдены в кургане, в котором захоронены три человека.
Каждая тонкая трубка простирается чуть более чем на один метр. Четыре находки включают золотую или серебряную фигурку быка, пробитую отверстием, чтобы ею можно было скользить вверх и вниз по трубке. Значения, приписываемые соломинкам с фигурками или без них, неизвестны, говорит группа Трифонова.
Остатки с внутренней поверхности одной трубки, рядом с ее коническим кончиком, содержат гранулы крахмала ячменя, частицы злаков дикого или одомашненного растения и пыльцевое зерно липы, сообщают ученые в февральском журнале Antiquity. Это могли быть ингредиенты ароматизированного пива, хотя дальнейшая работа должна подтвердить, что остатки ячменя имеют повреждения, вызванные брожением.
Майкопцы, населявшие юг России и юго-восточную Европу, вероятно, имели культурные связи с шумерами, жившими вблизи Персидского залива, говорят исследователи. На более чем 4000-летних шумерских рисунках изображены люди, использующие длинные соломинки для питья из общих сосудов.
Майкопцы, вероятно, жили в России.
Пиво начали варить еще 13 000 лет назад на Ближнем Востоке. А оттиски печатей на глиняных табличках примерно 7 000 лет назад в Ираке и Иране изображают людей, пьющих с помощью соломинок.
Выпивка пива началась еще 13 000 лет назад на Ближнем Востоке.
-
Эти крошечные жуки летают быстро благодаря щетинкам на крыльях и странному, широкому ходу
Перокрылые жуки — одни из самых маленьких в мире летающих насекомых. Однако они могут летать со скоростью и ловкостью гораздо более крупных насекомых. Теперь ученые выяснили, как жуки это делают.
Широкий размах крыльев в сочетании с легкими, щетинистыми крыльями позволяет жукам эффективно перемещаться по воздуху, сообщают исследователи 19 января в журнале Nature.
Некоторые виды перьевых жуков особенно миниатюрны; два таких насекомых, поставленные друг на друга, едва достигают толщины кредитной карты. При таких маленьких размерах воздух становится вязким, и трение воздуха становится серьезным препятствием для полета. Однако предыдущие исследования энтомолога Алексея Полилова из Московского государственного университета имени М.В. Ломоносова в России и его коллег показали, что эти насекомые могут летать со скоростью, сравнимой со скоростью жуков в три раза больше.
Полилов и его команда исследовали эту способность летать дальше, изучая одного из самых маленьких жуков-пернатых, Paratuposa placentis, используя высокоскоростное видео и вычислительное моделирование.
Способ жука бить крыльями не похож ни на один из ранее описанных, обнаружили специалисты. Его крылья образуют широкую восьмерку, хлопая друг о друга в верхней части своего взмаха для уменьшения сопротивления и снова встречаясь в нижней части взмаха. Это широкое движение дает жуку дополнительную силу, чтобы проталкиваться через воздух.
Как ни странно, крылья жука состоят из щетинок. Из-за трения воздуха при таких малых размерах эти щетинки позволяют крыльям иметь такую же силу махания, как крылья из мембран, например, у комнатной мухи, но при гораздо меньшей массе.
Кроме того, крылья жука имеют большую массу.
Предки жуков были крупнее своих современных сородичей. Полученные результаты позволяют понять, как насекомые могут сохранять важные спортивные способности при уменьшении размеров.
Исследование показало, что жуки-пернатые были крупнее своих современных сородичей.
-
Устойчивость к противомикробным препаратам является одной из основных причин смертности во всем мире
Бактериальные инфекции, не поддающиеся лечению, являются одной из основных причин смерти во всем мире.
В 2019 году устойчивость к противомикробным препаратам стала причиной примерно 1,27 миллиона смертей, сообщают исследователи 19 января в журнале Lancet. В том году от бактериальных инфекций, не поддающихся лечению, умерло больше людей, чем от ВИЧ или малярии.
В целом, устойчивость бактерий к противомикробным препаратам сыграла роль в смерти примерно 4,95 млн человек во всем мире, включая 1,27 млн человек, непосредственно вызванных устойчивыми инфекциями, говорится в исследовании. Оценки основаны на анализе данных больниц, эпиднадзора и других источников, охватывающих 204 страны и территории, проведенном международной группой исследователей под названием Antimicrobial Resistance Collaborators.
Устойчивость к двум классам антибиотиков — бета-лактамам (к которым относится пенициллин) и фторхинолонам — была причиной более 70% смертей, вызванных устойчивостью. Эти препараты являются первой линией лечения многих бактериальных инфекций.
По данным исследователей, среди бактерий, ответственных за смертельные инфекции, вызванные устойчивостью к лекарствам, лидируют Escherichia coli, Klebsiella pneumoniae и Staphylococcus aureus. Эти патогены могут вызывать опасные инфекции в медицинских учреждениях у людей с ослабленной иммунной системой.
По всему миру 64 случая смерти на 100 000 человек были связаны с устойчивыми к лечению бактериальными инфекциями, а 16,4 случая смерти на 100 000 человек были вызваны такими инфекциями, как групп. Примечательно, что самые высокие показатели смертности наблюдались в западной части Африки к югу от Сахары: 114,8 смерти на 100 000 человек были связаны с устойчивостью бактерий к противомикробным препаратам, а 27,3 смерти на 100 000 человек были вызваны устойчивостью.
В целом, уровень смертности от бактериальной устойчивости к противомикробным препаратам был выше в местах с меньшими ресурсами здравоохранения. Это показывает, что при принятии решений необходимо учитывать региональные различия, говорит исследовательская группа. Ограничение использования антибиотиков для предотвращения резистентности является ключевым фактором во многих местах. Но, например, в западной части Африки к югу от Сахары расширение доступа к антибиотикам может снизить смертность от резистентности, поскольку антибиотики второго ряда, необходимые после отказа препаратов первого ряда, не так легко доступны.

Свежие комментарии